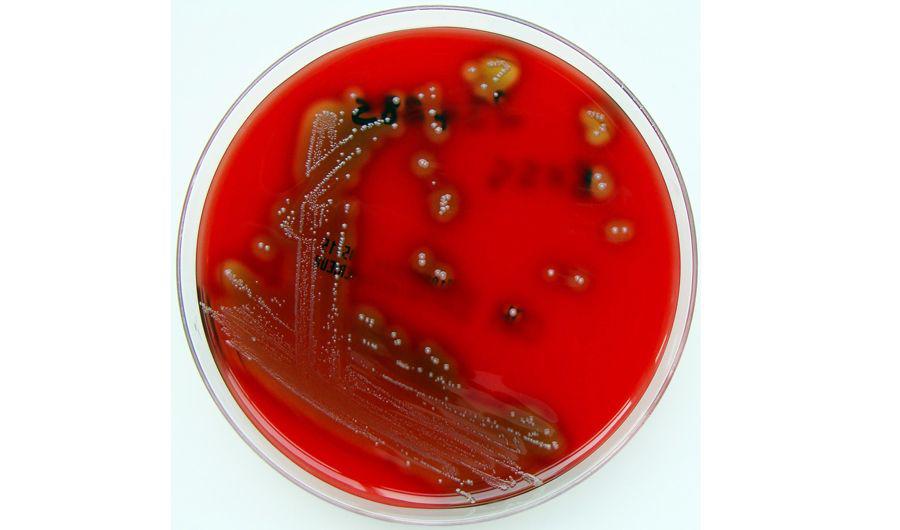
Cuaacuteles son los siacutentomas para consultar al meacutedico

Cuáles son los síntomas para consultar al médico Cuáles son los síntomas para consultar al médico
La Streptococcus pyogene es un germen común. Pero la muerte de cuatro chicos infectados con la bacteria encendió la alarma. La Secretaría de Salud emitió un alerta epidemiológica. Todos los afectados tenían entre 5 meses y 7 años, y no hay vacuna que prevenga la enfermedad.
El infectólogo Eduardo López, jefe del Departamento de Medicina del Hospital Ricardo Gutiérrez explicó que el alerta oficial tiene la finalidad de que, justamente, los médicos estén alerta y también la población, para consultar de manera temprana. La bacteria afecta a dos órganos, la garganta y la piel: allí se manifiesta y a esas señales hay que prestar atención. “Los síntomas son dos: cuando tienen faringitis, dolor de garganta, fiebre alta y dificultad para tragar, y cuando se brotan en la escarlatina o con lesiones de piel que se rascan o se duelen. Cuando ocurre eso, hay que consultar al médico”.
“Tranquilizamos a la gente diciendo que es muy raro que haya pasado lo que pasó con estos chicos. No es difícil diagnosticar esta enfermedad. Hay que concurrir rápido al hospital”, remarcó.